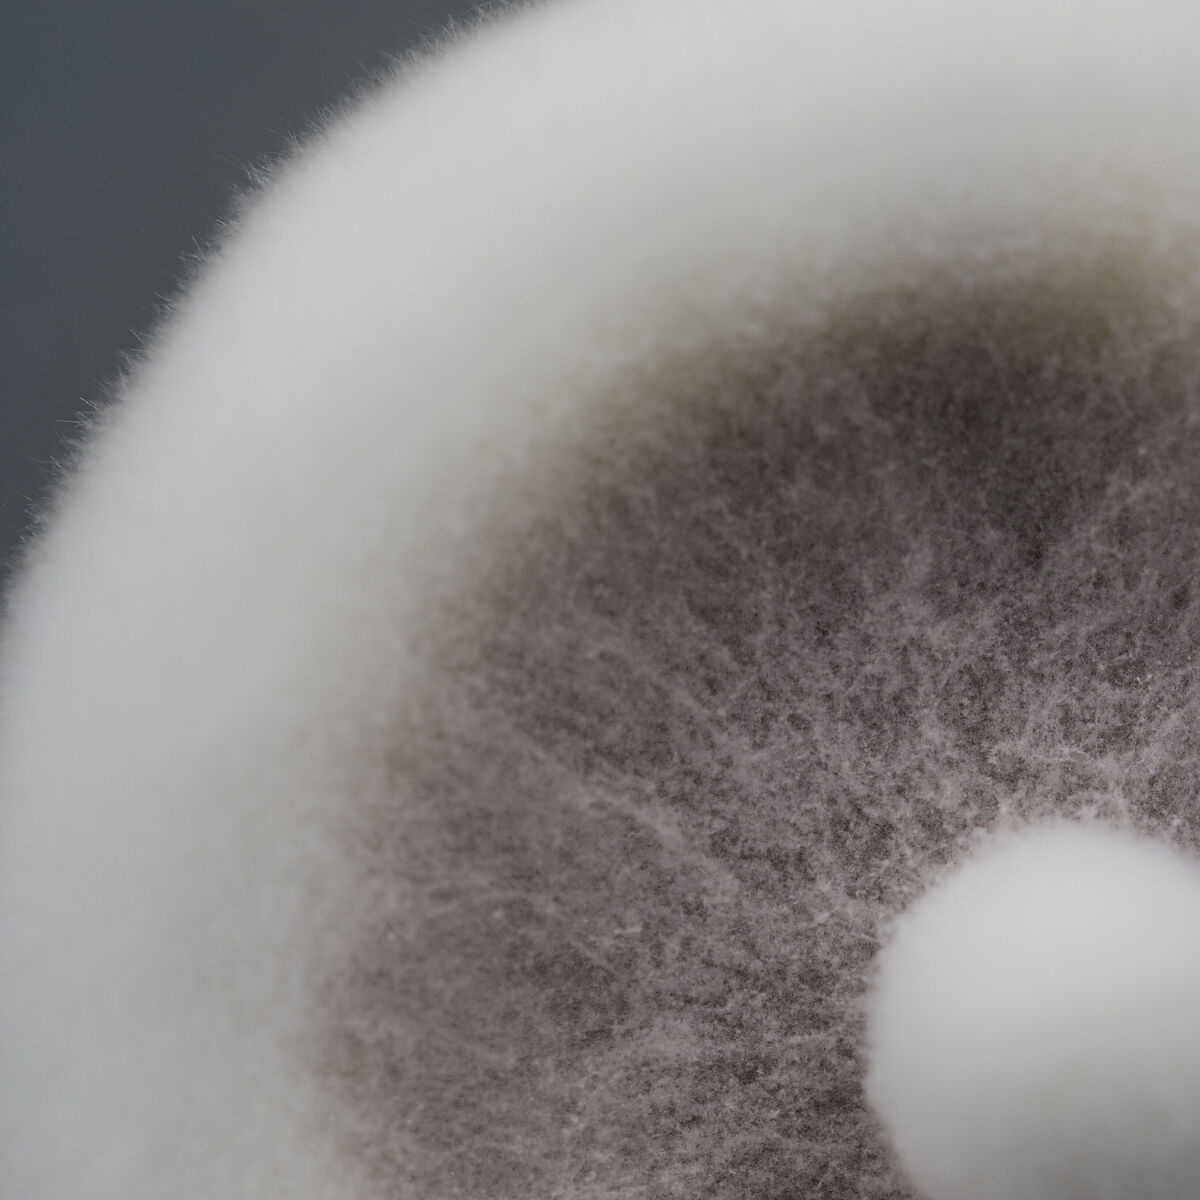

Contacto
Asociate con la naturaleza.
Completá este formulario para que uno de nuestros representantes se comunique con vos.
Biológico es Koppert: Nos asociamos con la naturaleza para lograr que la agricultura sea más sana, segura y productiva. Exploramos, formulamos y desarrollamos productos biológicos procedentes de la naturaleza. Porque las soluciones están en la tierra, siempre.
Elegí nuestro pack 100% biológico para combinar los beneficios de utilizar un promotor de crecimiento con la protección y eficiencia de un biofungicida y un bioprotector.
Mas información

11 3642 8464
[email protected]
11 5508 3302
[email protected]
11 3673 1988
[email protected]
351 203 2557
[email protected]
11 3673 1988
[email protected]
351 203 2557
[email protected]
11 3642 5606
[email protected]
Donde el verde brilla, allí estamos.
En este mapa podrás conocer las zonas de alcance de cada uno de nuestros responsables comerciales, quienes te informarán y asesorarán técnicamente sobre nuestras soluciones biológicas para la nutrición, protección y bioestimulación de tus cultivos.
ContactoAsociate con la naturaleza.
Completá este formulario para que uno de nuestros representantes se comunique con vos.